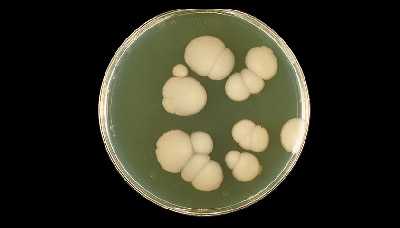
Кандида

Инфекции дрожжевых грибов - кандидоз: диагностика, лечение, профилактика
Добавил пользователь Morpheus Обновлено: 11.12.2025
Инвазивный кандидоз - тяжелая грибковая инфекция, вызванная грибами рода Candida, которая может проявляться кандидемией и/или вовлечением в процесс любых органов и систем ребенка [14, 29].
Этиология и патогенез
Candida spp. - одноклеточные дрожжеподобные грибы. Образуют псевдомицелий и мицелий. В настоящее время известно более 150 видов грибов рода Candida, среди которых основное значение, как возбудители кандидоза, имеют не более 10 видов (C.albicans, C.parapsilosis, C. lusitaniae, C. tropicalis и др.)[1, 35, 36].
Candida spp. - естественные обитатели кожи и слизистых оболочек человека. Грибковая инфекция возникает при локальных и системных нарушениях противоинфекционной защиты организма человека [26].
При эндогенном пути инфицирования происходит адгезия грибов на поверхности кожи и/или слизистых оболочках, которая сопровождается инвазией в поверхностные слои покровных тканей с поражением стенки лимфатических и кровеносных сосудов, что приводит к гематогенному (при иммунодефицитных состояниях - и лимфогенному) распространению микроорганизмов с последующей генерализацией инфекционного процесса и диссеминацией в ткани внутренних органов [1, 5, 21, 26, 28]. Может быть и негематогенный путь распространения, например, через слизистую оболочку ЖКТ в брюшную полость.
Экзогенный путь передачи грибов - через контаминированный хирургический инструментарий, внутрисосудистые катетеры, дренажи, при нарушении техники проведения парентерального питания [35]. В последние годы у недоношенных детей, получающих лечение в условиях ОРИТ, наряду с кандидозом стали выявлять случаи инфекций, связанных с оказанием медицинской помощи, вызванных другими дрожжеподобными грибами (Malassezia spp., Rhodotorula spp. и др.) [9, 13, 25].
Эпидемиология
По данным экспертной группы Российской ассоциации специалистов перинатальной медицины (РАСПМ) частота инвазивного кандидоза (ИК) у новорожденных в структуре инфекционно-воспалительных заболеваний составляет от 15 до 30%.
Частота возникновения ИК у новорожденных обратно пропорциональна сроку гестации и массе тела при рождении и составляет от 2,6% до 3,1% у новорожденных с очень низкой массой тела (ОНМТ) и от 10% до 16% у новорожденных с экстремально низкой массой тела (ЭНМТ) [7, 9, 19, 27]. В 10% случаев грибы рода Candida являются причиной нозокомиального сепсиса у детей с ЭНМТ при рождении, находящихся на лечении в условиях отделения реанимации и интенсивной терапии новорожденных (ОРИТН) [23].
Среди пациентов с ЭНМТ при рождении летальность на фоне ИК составляет 34% в сравнении с 14% у данной категории пациентов без ИК [38].
Показатель летальности при кандидемии составляет 20-40%, кандидозном менингите - 50%, а при поражении двух и более органов и/или систем данный показатель может увеличиваться до 57% [13, 15, 31, 38].
По данным литературы, кандидемию выявляют у 37-50% детей в сочетании с кандидозным менингитом [29, 31]. Частота изолированного кандидозного менингита при развитии инвазивного кандидоза у новорожденных достигает 10-20% [29].
Поражение почек диагностируют у 10-35% новорожденных на фоне кандидемии. Поражение почек как правило сопровождается кандидурией и, в ряде случаев, развитием почечной недостаточности [13, 17, 29].
Клиническая картина
Cимптомы, течение
Основными факторами риска развития инвазивных микозов у новорожденных являются [1, 9, 14, 21, 22, 28, 29, 30]:
1. Недоношенность (малый вес при рождении (менее 1000г) и малый гестационный возраст (менее 27 недель)
4. Терапия антимикробными препаратами широкого спектра действия, особенно цефалоспоринами третьего поколения и карбапенемами
9. Наличие кандидозной инфекции у матери во время настоящей беременности и родов.
К поверхностным кандидозам относят: кандидоз желудочно-кишечного тракта (ЖКТ) - кандидозный стоматит, глоссит, хейлит, гингивит, кандидоз верхних дыхательных путей, интертригинозный (пеленочный дерматит).
Клинические проявления поверхностного кандидоза зависят от локализации очага поражения. Поражение кожи может выглядеть как интертригинозный или пеленочный дерматит, наиболее характерный для новорожденных. Поражение слизистой оболочки наиболее часто происходит в ротовой полости (молочница). Клиническая картина развивается чаще всего на 5-14 день жизни. Помимо молочницы возможно развитие стоматита, глоссита, хейлита и гингивита [6, 16, 17].
Кандидоз ЖКТ занимает третье место по частоте выявляемости у доношенных новорожденных, но находится на первом месте у недоношенных детей. При кандидозе ЖКТ у ребенка отмечаются диспептические явления различной степени выраженности [29]. У новорожденных отмечены случаи перфорации кишечника с развитием кандидозного перитонита [32]. Следует отметить, что развитие поверхностного кандидоза верхних дыхательных путей наиболее вероятно у новорожденных, находящихся на традиционной ИВЛ [3,13]. Для кандидоза мочеполовой системы характерны умеренный лейкоцитоз, незначительная протеинурия, наличие дрожжевых клеток и/или псевдомицелия гриба в моче. При УЗИ возможно обнаружение «грибных шаров», вызывающих обструкцию мочевых путей, что может приводить к затруднению оттока мочи, вплоть до развития олигурии [29, 32]. При выявлении Candida spp. в моче обязательно следует исключить наличие ИК.
Клиническая картина ИК неспецифична и имеет все признаки воспалительного процесса. Наблюдаются как локальные, так и общие симптомы инфекции. О развитии ИК могут свидетельствовать нарастание признаков инфекционного токсикоза вплоть до появления полиорганной недостаточности [10]. Диссеминированный кандидоз (грибковый сепсис), протекает в виде кандидемии либо в сочетании кандидемии и поражения внутренних органов. Частота развития кандидемии у новорожденных обратно пропорциональна сроку гестации и массе тела при рождении и составляет у новорожденных с ОНМТ при рождении 2-6,8% , в то время как у новорожденных с ЭНМТ - достигает 16% [30]. Заболеваемость ИК увеличивается с 3% в 28 недель гестации до 24% при 24 неделях гестации [32]. По данным ряда авторов, среди пациентов с ЭНМТ при рождении частота кандидемии составляет 7%, при этом показатели летальности могут достигать 30% [20]. Очень важно, что кандидемия часто является промежуточным этапом в процессе диссеминации грибов, поэтому функциональные методы диагностики, такие как ЭХО-КГ, нейросонография, офтальмоскопия, УЗИ почек, являются необходимыми диагностическими мероприятиями у новорожденных.
При развитии кандидозного менингита клинические проявления в первые дни и недели заболевания выражены незначительно, отмечаются признаки медленно нарастающего гипертензионного или гипертензионно-гидроцефального синдрома. Характерна глазная симптоматика: симптом Грефе, нистагм, страбизм. Температурная реакция может отсутствовать или быть субфебрильной [3]. В ряде случаев, отмечаются характерные изменения при исследовании спиномозговой жидкости (СМЖ): при умеренном повышении показателей цитоза наблюдается значительное повышение содержания белка [16]. Тем не менее, при исследовании СМЖ, после проведения люмбальной пункции показатели находятся в пределах нормативных значений у половины новорожденных с кандидозным менингитом. Летальность при подтвержденных грибковых менингитах высока и может достигать 50% [16]. При ИК у новорожденных в 1-10% случаев отмечается явления кандидозного эндокардита [31]. Чаще повреждаются митральный и трикуспидальный клапаны, возможно повреждение миокарда и перикарда. Симптомы заболевания сходны с бактериальным эндокардитом. На ЭКГ отмечаются признаки перегрузки правых отделов. По данным ЭХО-КГ обнаруживают типичные признаки эндокардита [17, 29, 32]. На фоне длительной кандидемии (>5 дней) возможно развитие грибкового поражения печени и селезенки [17, 29, 32], а также развитие кандидозного остеомиелита или остеоартрита [29,32]. У новорожденных также отмечены случаи перфорации кишечника с развитием кандидозного перитонита [32].
Диагностика
- использования антибактериальных, гормональных, цитостатических препаратов. Необходимой также является информация о том, выполнялись ли бактериологические посевы матери во время беременности и о полученных результатах.
При подозрении на грибковую инфекцию необходимо проводить осмотр новорожденного в родильном блоке и в неонатальных отделениях (реанимация и интенсивная терапия, патология новорожденных, хирургия новорожденных) на наличие клинических проявлений кандидоза в виде поражений кожи и слизистых оболочек, признаков инфекционного токсикоза (бледность, сероватый колорит кожных покровов, и др.), диспептических расстройств (вздутие живота, ослабление перистальтики, нарушение усвоения энтерального питания), признаков нарушения мочеотделения (олиго - и/или анурия), дыхательных нарушений (бради - и/или тахипноэ, апноэ, лабильность сатурации, нарастания потребности в кислороде, потребности в проведении респираторной терапии) и гемодинамических расстройств (тахи - и/или брадикардия, артериальная гипотензия), наличие желтухи, гепатоспленомегалии.
а) Посев крови является «золотым стандартом» диагностики системных инфекций у новорожденных, включая инвазивный кандидоз. Согласно рекомендациям ESCMID 2012 года при подозрении на развитие кандидемии следует осуществлять посев крови у новорожденных в количестве не менее 2 мл не менее 2 раз в сутки в течение 3 дней подряд. Однако, учитывая значительные технические трудности, связанные с осуществлением пункций интактных вен у недоношенных новорожденных, а также, принимая во внимание величину объема циркулирующей крови у детей с ОНМТ и ЭНМТ при рождении 80-90 мл на 1 килограмм массы тела, допускается взятие от 1,0 до 2 мл крови на одно исследование. При этом сбор необходимого объема крови производится в соответствии с инструкцией производителя флаконов для гематологических анализаторов.
б) При подозрении на развитие кандидоза мочевыделительной системы необходимо осуществить посев мочи, собранной через стерильный мочевой катетер.
г) При выявлении кандидемии следует исключить поражение почек и ЦНС. При подозрении на развитие инвазивного кандидоза ЦНС - необходимо проведение люмбальной пункции с последующим культуральным исследованием СМЖ.
Посевы крови, СМЖ, асцитической и плевральной жидкостей производят с использованием флаконов с жидкой питательной средой для культивирования в автоматических гематологических анализаторах. При наличии в лаборатории масс-спектрометра рекомендуется проведение прямой идентификации грибов из положительной гемокультуры методом MALDI-TOF-MS анализа, при отрицательном результате осуществление высева на плотные питательные среды с последующей биохимической или MALDI-TOF-MS идентификацией выросших колоний грибов [11, 12, 14]. Для видовой дифференцировки видов грибов допускается использование хромогенных сред (различные виды грибов образуют на поверхности питательного агара колонии различных цветов). Окраска колоний зависит от производителя питательной среды, оценку видовой принадлежности грибов проводят в соответствии с инструкцией производителя.
Колонизация нескольких локусов (3-х и более) - является независимым фактором риска и предиктором прогрессирования для грибкового сепсиса (Manzoni P. 2006).
д) При выявлении кандидемии следует исключить поражение почек и ЦНС. При подозрении на развитие инвазивного кандидоза ЦНС - необходимо проведение люмбальной пункции с последующим культуральным исследованием СМЖ [37]. Посевы крови, СМЖ, асцитической и плевральной жидкостей производят с использованием флаконов с жидкой питательной средой для культивирования в автоматических гематологических анализаторах. При наличии в лаборатории масс-спектрометра рекомендуется проведение прямой идентификации грибов из положительной гемокультуры методом MALDI-TOF-MS анализа, при отрицательном результате осуществление высева на плотные питательные среды с последующей биохимической или MALDI-TOF-MS идентификацией выросших колоний грибов [11, 12, 13, 14].
Уровень убедительности рекомендаций С (уровень достоверности доказательств - 3).
б) Методики определения 1,3 -b-D-глюкана и антител против ростовых трубок C. albicans (CAGTA) в настоящее время проходят процесс регистрации в РФ и не могут быть использованы в клинической практике [1].
а) Компьютерная томография головного мозга, легких и/или органов брюшной полости высокого разрешения.
Вагинальный кандидоз (молочница) - симптомы и лечение
Что такое вагинальный кандидоз (молочница)? Причины возникновения, диагностику и методы лечения разберем в статье доктора Сосниной Анастасии Сергеевны, гинеколога со стажем в 15 лет.
Над статьей доктора Сосниной Анастасии Сергеевны работали литературный редактор Вера Васина , научный редактор Сергей Федосов и шеф-редактор Лада Родчанина
Определение болезни. Причины заболевания
Вагинальный кандидоз (кандидозный вагинит) — поражение слизистой оболочки влагалища дрожжеподобными грибами рода Candida. В быту эту болезнь называют молочницей .
Краткое содержание статьи — в видео:
Candida — это условно-патогенные микроорганизмы, факультативные анаэробы (организмы, способные жить как в присутствии кислорода, так и без него). Они обладают тропизмом — направлением роста на клетки богатые гликогеном, в частности клетки слизистой оболочки влагалища. Самый распространённый вид возбудителя, который встречается в 70—90 % случаев, — Candida albicans.
В последние годы растёт заболеваемость кандидозом, вызванным другими представителями рода Candida. Наиболее часто выявляются:
- С. glabrata (15 %);
- C. dubliniensis (6 %);
- C. tropicalis (3—5 %);
- C. parapsilosis (3 %);
- C. krucei (1—3 %).
Распространение новых видов микроорганизмов связано в первую очередь с бесконтрольным самолечением пациенток, приводящем к возрастающей устойчивости грибов к препаратам [3] [4] .
Частота кандидозного вагинита среди инфекционных заболеваний влагалища и вульвы составляет 30—45 %. Патология занимает второе место среди всех инфекционных заболеваний влагалища и является крайне распространённым поводом для обращения женщин за медицинской помощью. По данным J. S. Bingham (1999):
- к 25 годам около 50 % женщин репродуктивного возраста сталкивались с хотя бы одним диагностированным врачом эпизодом вагинального кандидоза;
- к началу периода менопаузы — около 75 % [17] .
Кандидозный вагинит редко наблюдается в постменопаузе, за исключением тех пациенток, которые получают гормональную заместительную терапию.
Предрасполагающими факторами заболевания являются:
- Механические — ношение синтетического белья, первый половой контакт, травматическое повреждение тканей влагалища, длительное применение внутриматочной спирали.
- Физиологические — беременность, менструация.
- Эндокринные — гипотиреоз, сахарный диабет.
- Иммунодефицитные состояния.
- Ятрогенные (приём антибиотиков, кортикостероидов, иммуносупрессоров, лучевая терапия, химиотерапия, онкологические заболевания, оральные контрацептивы).
- Прочие (авитаминоз, аллергические заболевания, хронические патологии гениталий и желудочно-кишечного тракта).
Заболевание, как правило, не передаётся половым путём, но установлено, что оно связано с характером половых контактов: анально-вагинальным и орогенитальным. Также не исключается вероятность развития кандидозного баланопостита у половых партнёров пациенток с вагинальным кандидозом.
При обнаружении схожих симптомов проконсультируйтесь у врача. Не занимайтесь самолечением - это опасно для вашего здоровья!
Симптомы вагинального кандидоза
Основные симптомы при вагинальном кандидозе:
- жжение и зуд в области влагалища и вульвы;
- творожистые выделения из влагалища;
- расстройства мочеиспускания;
- боль при половом акте.
Зуд может усиливаться после водных процедур, полового акта, ночью во время сна и в период менструации [1] .
В целом симптомы вагинального кандидоза нарастают перед менструацией. При беременности проявление болезни также усугубляется, это связано со снижением иммунитета у беременных женщин.
Объективные признаки вагинального кандидоза:
- отёк и гипермия слизистой оболочки влагалища и наружных половых органов;
- белые или зеленовато-белые наложения на стенках влагалища;
- покраснение слизистой влагалища.
При осложнённом кандидозе на коже наружных половых органов появляются везикулы — пузырьки, возвышающиеся над уровнем кожи или слизистой и заполненные прозрачным или мутным содержимым, которые могут вскрываться и образовывать эрозии. При вагинальном кандидозе также могут наблюдаться трещины слизистой вульвы, задней спайки и перианальной области [2] .
Патогенез вагинального кандидоза
Грибы рода Candida относятся к условно-патогенной микрофлоре, которая присутствует как в окружающей среде, так и на поверхности кожных покровов и слизистых оболочках здорового человека (в полости рта, кишечнике, влагалище). При снижении защитных сил организма возможно повышение адгезивных свойств (способности прилипать) грибов с прикреплением их к клеткам эпителия влагалища, колонизацией слизистой оболочки и развитием воспалительной реакции [7] .
Вагинальный кандидоз зачастую затрагивает только поверхностные слои эпителия влагалища без проникновения возбудителя в более глубокие слои слизистой оболочки. Однако в редких случаях эпителиальный барьер преодолевается и происходит инвазия в подлежащую ткань с последующей гематогенной диссеминацией (распространением возбудителя инфекции из первичного очага заболевания по всему органу или организму посредством кровотока) [8] [9] .
Основные этапы патогенеза:
- Адгезия (прилипание) грибов на слизистой и колонизация.
- Инвазия (проникновение) в эпителий.
- Преодоление эпителиального барьера.
- Проникновение в соединительную ткань.
- Преодоление защитных механизмов ткани.
- Попадание в сосуды.
- Гематогенная диссеминация.
При вагинальном кандидозе воспаление происходит в верхних слоях эпителия влагалища. Причина состоит в том, что поддерживается динамическое равновесие между грибом, который не может проникнуть в более глубокие слои, и организмом, который сдерживает его распространение. Соответственно инфекция может долго развиваться в одном месте, проявляясь творожистыми выделениями из влагалища. Обострение заболевания происходит при сдвиге равновесия между развитием грибов и защитными силами организма.
Классификация и стадии развития вагинального кандидоза
Согласно национальным клиническим рекомендациям [18] , выделяют две формы вагинального кандидоза:
- острую — до трёх обострений в год;
- хроническую (рецидивирующую) — не менее четырёх обострений в год.
По классификации, предложенной D.A. Eschenbach, вагинальный кандидоз подразделяют на два типа:
У женщин различают три формы заболевания:
- вагинит (воспаление влагалища); (воспаление влагалища и вульвы); (воспаление шейки матки).
У мужчин выделяют:
- баланит (воспаление головки полового члена);
- баланопостит (воспаление крайней плоти и головки полового члена); (воспаление мочеиспускательного канала).
Для острой формы вагинального кандидоза характерны выраженные симптомы: обильные выделения из влагалища, жжение и зуд во влагалище и наружных половых органах. На фоне таких симптомов нередко снижается трудоспособность пациентки и развиваются неврозы. Острая форма вагинального кандидоза встречается наиболее часто и формируется в результате увеличения количества грибов рода Candida во влагалище на фоне снижения иммунитета пациентки.
Рецидивирующий вагинальный кандидоз — встречается у 10—15 % женщин репродуктивного возраста и проявляется четырьмя и более обострениями за год [11] .
Неосложнённая форма заболевания предполагает впервые выявленный или возникающий менее четырёх раз в год вагинальный кандидоз с умеренными проявлениями вагинита у пациенток без сопутствующих факторов риска (сахарный диабет, приём глюкокортикоидов, цитостатиков и др.).
При осложнённом вагинальном кандидозе наблюдаются яркие объективные симптомы: покраснение, отёк, образование язв, трещин слизистых оболочек и кожи перианальной области. Также характерны рецидивы четыре и более раз в год. Заболевание часто возникает на фоне сахарного диабета, ВИЧ-инфекции, терапии глюкокортикоидами и цитостатиками. Возбудителем заболевания в данном случае являются как C. albicans, так и другие грибы рода Candida.
Осложнения вагинального кандидоза
К осложнениям вагинального кандидоза у женщин относятся:
- стеноз влагалища;
- воспалительные патологии органов малого таза — сальпингит, оофорит и другие;
- заболевания мочевыделительной системы — цистит, уретрит[2] .
Стеноз влагалища развивается при воспалении стенок влагалища. При этом просвет влагалища сужается, а стенки влагалища становятся плохо растяжимы. Пациентки испытывают боль при половом акте.
Сальпингит — инфекционно-воспалительное заболевание фаллопиевой (маточной) трубы. Возникает при переходе инфекции восходящим путем из влагалища, не исключен также и гематогенный путь передачи. Сальпингит чаще всего протекает в сочетании с оофоритом — воспалением яичника. Поражение может быть как односторонним, так и двусторонним. Пациентки испытывают боль в области придатков, внизу живота слева или справа, повышается температура тела, возникает общее недомогание, слабость, а иногда и тошнота со рвотой. При несвоевременном лечении данного осложнения высок риск бесплодия, наступления внематочной беременности, возникновения спаечного процесса, приводящего к оперативному вмешательству, инфицированию органов брюшины и малого таза. Сальпингит особенно опасен в случаях, когда с кандидозом сочетаются другие инфекции [1] .
Уретрит — воспаление слизистой мочеиспускательного канала. Проявляется болезненным мочеиспусканием, чувством жжения в области уретры, выделением с мочой крови или гноя, дискомфортом при соприкосновении с бельём, слипанием краёв уретры, покраснением области вокруг мочеиспускательного канала.
Цистит — воспаление мочевого пузыря. Патология возникает при попадании возбудителя восходящим путём через уретру в мочевой пузырь. Симптомы цистита схожи с симптомами уретрита, однако есть некоторые отличия: частые позывы к мочеиспусканию при небольшом количестве мочи, чувство неполного опорожнения мочевого пузыря, боль, резь в конце мочеиспускания, помутнение мочи, повышение температуры тела, боли внизу живота.
На фоне вагинального кандидоза возрастает частота осложнений при беременности, а также увеличивается риск инфицирования плода.
Кандидоз плода может вызвать его внутриутробную гибель или приводить к преждевременным родам. После родов у женщин возможно развитие кандидозного эндометрита — воспалительного процесса в тканях, выстилающих внутреннюю полость матки.
Диагностика вагинального кандидоза
Диагностика вагинального кандидоза основывается на характерных жалобах пациентки, данных анамнеза, клинических проявлениях, выявленных при гинекологическом осмотре. В зеркалах видна гиперемия, отёк слизистой, белые налёты на стенках влагалища.
Независимо от этих признаков, подтверждение диагноза должно основываться на лабораторных данных:
- Микроскопия мазков вагинального отделяемого — позволяет выявить споры и мицелий гриба.
- Культуральный метод — посев влагалищного содержимого на искусственные питательные среды. Метод определяет количество, видовую принадлежность, чувствительность к противогрибковым препаратам, а также характер и степень заселения другими микроорганизмами. Культуральный метод дополняет микроскопию.
- Серологическая диагностика (РСК). Определяет антитела против антигенов грибов рода Candida. Такая диагностика имеет значение при генерализации процесса.
- Молекулярно-биологические методы. Направлены на обнаружение специфических фрагментов ДНК Candida spp. Применяют метод полимеразной цепной реакции (ПЦР).
- Иммунофлюоресцентная диагностика (Candida Sure Test) проводится в случае рецидивирующего течения вагинального кандидоза [15] .
К дополнительным методам диагностики относятся: изучение микробиоценоза кишечника, обследование на инфекции, передаваемые половым путём, внутривенный тест на толерантность к глюкозе [16] .
Дифференциальную диагностику проводят со следующими заболеваниями:
- генитальным герпесом; ;
- аэробным вагинитом;
- кожными заболеваниями (экземой, красным плоским лишаём, склеродермией, болезнью Бехчета и др.).
Лечение вагинального кандидоза
Показаниями к назначению терапии вагинального кандидоза являются жалобы пациентки, клинические проявления и лабораторное подтверждение наличия грибов рода Candida. Лечение не требуется при обнаружении грибов без каких-либо клинических проявлений (кандидозоносительство). Это правило обусловлено тем, что грибы рода Candida могут содержаться в небольшом количестве во влагалище и являются частью нормальной микрофлоры, если их количество не превышает пороговое значение 10 4 .
Механизм действия противогрибковых препаратов — нарушение синтеза эргостерола (вещества в составе клеточных мембран грибов), что приводит к образованию дефектов в мембране микроорганизма. В зависимости от дозы антимикотики проявляют фунгистатическое (замедление роста) или фунгицидное (полное уничтожение) действие [15] .
Существуют различные группы препаратов для лечения вагинального кандидоза:
- антибиотики (пимафуцин, амфотерицин В, нистатин, леворин);
- имидазолы (клотримазол, сертаконазол, кетоконазол, гино-певарил, миконазол);
- триазолы (итраконазол, флуконазол);
- комбинированные препараты ("Тержинан", "Полижинакс", "Пимафукорт", "Клион Д", "Макмирор комплекс");
- препараты разных групп (флуцитозин, гризеофульвин, дафнеджин, нитрофунгин, йодат поливинилпирролидон).
Лечение подбирается гинекологом индивидуально для каждой пациентки, учитывая клиническую картину, форму заболевания и степень выраженности симптомов. Но важно отметить, что при лечении молочницы при беременности флуконазол противопоказан, так как он может негативно повлиять на развитие плода [19] [20] .
При лечении острых форм вагинального кандидоза назначают местное лечение. Препарат не всасывается в системный кровоток, а действует в области влагалища и слизистой. Примеры схем лечения:
- 150 мг в виде вагинальных свечей один раз в сутки в течение трёх дней; один аппликатор крема на ночь вагинально в течение трёх дней; одна свеча на ночь один раз в сутки в течение восьми дней; одна таблетка на ночь в течение 10 дней.
При хроническом кандидозе наряду с местным лечением применяют системные антимикотики:
- 150 мг один раз внутрь; 200 мг внутрь два раза с интервалом 12 часов в течение одного дня или 200 мг в сутки в течение трёх дней.
- физиологического снижения иммунитета (период новорожденности или пожилой возраст, сильный стресс, беременность);
- врожденного иммунодефицита (синдром Di George, Nezelof и др.);
- онкопатологии, особенно в период полихимиотерапии;
- аутоиммунных и аллергических заболеваний (усугубляет угнетение иммунитета лечение кортикостероидными гормонами);
- приема иммунодепрессантов после трансплантации органов;
- тяжелых эндокринных заболеваний, соматической патологии, требующей интенсивной терапии;
- длительного лечения антибактериальными препаратами резервного ряда;
- синдрома первичного иммунодефицита;
- выраженного дисбаланса питательных веществ в рационе (особенно недостатка белка и витаминов).
- Экзогенные (внешние) факторы, способствующие проникновению грибков в организм:
- профессиональные вредности, приводящие к частым повреждениям кожи;
- длительное пребывание в теплой и влажной среде;
- нарушение целостности слизистых оболочек.
- Факторы, приводящие к снижению сопротивляемости организма:
- наличие хронических заболеваний;
- длительный прием препаратов, способствующих нарушению естественной микрофлоры;
- несбалансированное питание;
- частые стрессы, нарушения режима сна и отдыха.
- Нарушения обмена веществ (гиповитаминозы), заболевания иммунной системы (ВИЧ-инфекция), эндокринные патологии (сахарный диабет и пр.).
- Длительный прием некоторых препаратов: гормональных контрацептивов, системных глюкокортикостероидов, антибиотиков широкого спектра действия, цитостатиков.
- Длительное пребывание или проживание в местности с повышенной влажностью и температурой, комфортными для циркуляции спор грибков в окружающей среде.
- Урогенитальный кандидоз.
- Кандидоз слизистой оболочки полости рта.
- Поверхностный кандидоз.
- Межпальцевый кандидоз.
- Кандидоз околоногтевых валиков и ногтей.
- Кандидоз желудочно-кишечного тракта.
- Появление бело-желтых творожистых или сливкообразных выделений из половых путей. Интенсивность выделений может усиливаться перед менструацией, что связано с изменением гормонального фона.
- Неприятные ощущения, зуд в области гениталий, зачастую усиливающиеся при половом контакте или мочеиспускании.
- Покраснение и отечность слизистой вульвы и влагалища, наличие повреждений на коже половых органов (трещины, микротравмы).
- При хроническом течении УГК развивается сухость слизистых оболочек половых путей.
- Покраснение, отечность, неприятные ощущения в области половых органов.
- Беловатые выделения творожистой структуры из половых путей.
- Боль и жжение при половом контакте и при мочеиспускании.
- тяжёлые инфекционные заболевания, которые сопровождаются снижением иммунитета, например ВИЧ-инфекция;
- хронические эндокринные нарушения — сахарный диабет, снижение функции щитовидной железы;
- изменения гормонального фона из-за беременности или лечения гормональными препаратами;
- терапия антибиотиками.
- Неинвазивный — наиболее распространённая форма. Грибы активно размножаются в просвете кишечника, не проникая в ткани.
- Инвазивный может возникать на фоне других заболеваний кишечника, например язвенной болезни. Грибковая инфекция проникает в ткани в местах нарушения слизистой оболочки.
- Диссеминированный (кандидемия) встречается у людей с иммунодефицитом. Грибковая инфекция проникает в кровоток и поражает внутренние органы.
- вздутие живота;
- боль в животе;
- разжижение стула;
- повышение температуры (редко);
- признаки интоксикации — головная боль, тошнота, озноб (редко);
- признаки поражения других органов пищеварения (редко).
При рецидивирующей форме заболевания (более четырёх эпизодов в год) применяют схему:
- 150 мг внутрь три раза с интервалом 72 часа в 1,4 и 7 день лечения.
Для купирования рецидивов препарат применяют в дозировке 150 мг один раз в неделю в течение шести месяцев.
В последние годы всё больше исследуется способность C. albicans формировать биоплёнки — вещества на поверхности колонии микроорганизмов, которые служат барьером для проникновения лекарственных средств и обеспечивают выживание. Основным полисахаридом, определяющим развитие резистентности к антибиотикам, является глюкан. Его рассматривают как одну из причин формирования резистентности к антимикотическим препаратам. Этим объясняется отсутствие эффекта при лечении у некоторых больных. Таким пациенткам можно порекомендовать препарат фентиконазол 600 мг в сутки с интервалом в три дня. Лекарство отличается от других способностью преодолевать биоплёнки, тем самым повышая эффективность лечения при резистентности к другим препаратам.
Прогноз. Профилактика
При своевременном обращении пациентки к врачу, лабораторном обследовании и отсутствии самолечения прогноз благоприятный. Самолечение опасно из-за риска рецидива заболевания, его хронизации и возникновения резистентности к препарату, неверно выбранному пациенткой или при неадекватной дозе.
Чтобы повысить эффективность терапии пациентки должны следовать схеме лечения, индивидуально назначенной гинекологом. Во время лечения и диспансерного наблюдения необходимо соблюдать половой покой или применять барьерные методы контрацепции. Повторно обратиться к врачу для контроля анализов следует через 7-10 дней [12] .
Кандидоз кишечника
Кандидоз кишечника - инфекционное поражение пищеварительного тракта, вызванное собственной грибковой флорой пациента (Candida spp.) на фоне значительного ослабления иммунитета. Клинические проявления кандидоза кишечника варьируют в зависимости от формы заболевания: разжижение стула, повышенный метеоризм, неопределенные боли в животе, язвенный колит и грибковый сепсис. Диагноз ставится на основании эндоскопического исследования, гистологического и культурального анализа биоптатов, кала. Лечение включает три основных направления: назначение антимикотиков, нормализацию микрофлоры кишечника и коррекцию иммунного статуса пациента.

Общие сведения
Кандидоз кишечника - грибковое поражение слизистой оболочки пищеварительного тракта. Является актуальной проблемой современности, так как диагностика и определение критериев данного заболевания представляют сложность для многих клиницистов. Связано это с повсеместной распространенностью грибов рода Candida, в том числе и в организме здоровых людей (носительство грибов рода Candida в кишечнике присуще 80% населения). Инвазивный кандидоз кишечника практически никогда не встречается у людей с нормально функционирующим иммунитетом, почти всегда это оппортунистическая инфекция, связанная с иммунным дисбалансом организма.
Кроме того, для многих специалистов бывает достаточно сложно дифференцировать транзиторное кандидоносительство и неинвазивный кандидоз кишечника (именно он составляет подавляющее большинство всех клинических случаев кандидоза пищеварительной системы). Разграничить два этих состояния возможно только при наличии современного диагностического оборудования. Для установления правильного диагноза необходимо наличие трех диагностических критериев: выявление одного или нескольких факторов риска, эндоскопические признаки кандидоза кишечника, положительный результат культурального исследования. Таким образом, тактика назначения антимикотиков при первом обнаружении в посевах грибов рода Candida, без дальнейшего обследования, является ошибочной.
Причины кандидоза кишечника
Специалисты в области гастроэнтерологии выделяют две патогенетические формы кандидоза кишечника - инвазивную и неинвазивную. В клинической практике чаще встречается неинвазивный кандидоз кишечника на фоне дисбактериоза и смешанной кишечной инфекции (грибково-бактериальной, грибково-протозойной и др.). Висцеральная форма развивается на фоне выраженной нейтропении (практически полное отсутствие нейтрофильных лейкоцитов) и поздних стадий СПИДа.
Факторы риска
Для формирования кандидоза кишечника необходимо наличие хотя бы одного из предрасполагающих факторов:
В клинической практике чаще встречается кандидоз кишечника, обусловленный сочетанием нескольких из перечисленных факторов.
Патогенез
При неинвазивной форме грибы рода Candida начинают неконтролируемо размножаться в просвете кишки, не проникая в толщу ее слизистой. При этом выделяются специфические грибковые токсины, образуются ядовитые продукты ферментации, оказывающие раздражающее действие на слизистую оболочку кишечника. Перечисленные токсические агенты провоцируют дальнейшее усугубление дисбиоза, формирование микотической аллергии, вторичного иммунодефицита.
Патогенез инвазивного кандидоза кишечника иной. При условии ослабления местного и общего иммунитета грибы рода Candida интимно прикрепляются к эпителию кишечника (они имеют тропность к плоскому многослойному эпителию), затем внедряются в его толщу, трансформируясь в нитчатую форму. При наличии выраженной супрессии клеточного иммунитета Candida проникают в кровоток и распространяются по организму, вызывая висцеральный кандидоз (поражение печени, поджелудочной железы).
Симптомы кандидоза кишечника
Кандидоз кишечника встречается в трех основных клинических формах: инвазивный диффузный, инвазивный фокальный и неинвазивный. Критериями диагностики инвазивного диффузного кандидоза кишечника являются тяжелое состояние пациента на фоне выраженной интоксикации, повышение температуры тела, сильная боль в животе, диарея, примесь крови в стуле, системные проявления микоза (поражение печени, поджелудочной железы, селезенки, желчного пузыря и др.). Если эта форма кандидоза кишечника является случайной находкой во время обследования по поводу других заболеваний, в первую очередь следует думать о дебюте СПИДа или сахарного диабета. Инвазивный диффузный кандидоз кишечника не характерен для людей с нормально функционирующей системой иммунитета.
Инвазивный фокальный кандидоз кишечника может осложнять течение язвенной болезни двенадцатиперстной кишки, неспецифического язвенного колита. Заподозрить данную форму кандидоза можно у пациентов с упорным и затяжным течением фонового заболевания, не поддающегося стандартной терапии. Для этого варианта микоза характерна локальная инвазия нитчатой формы Candida в местах нарушенной эпителизации (на дне язв кишечника). При этом в окружающих тканях, других отделах кишки друзы грибов не выявляются. Клиническая картина соответствует основному заболеванию, а псевдомицелий обнаруживается случайно при гистологическом исследовании биоптатов.
Неинвазивный кандидоз кишечника является наиболее распространенной формой данного заболевания. Эта патология не ассоциируется с проникновением грибов в толщу кишечной стенки, а связана с массивным размножением Candida в просвете кишки. При этом выделяется огромное количество токсичных метаболитов, которые оказывают как местное, так и общее резорбтивное действие. Сегодня установлено, что неинвазивный кандидоз составляет примерно треть всех случаев дисбиоза кишечника. Клинически неинвазивный кандидоз кишечника протекает на фоне удовлетворительного состояния пациента, сопровождается умеренными явлениями интоксикации, дискомфортом в животе, метеоризмом, неустойчивым стулом. Часто у таких больных обостряются различные аллергические заболевания. Эту форму кандидоза зачастую путают с синдромом раздраженного кишечника.
Диагностика кандидоза кишечника затрудняется отсутствием типичных клинических признаков, а также достаточно специфичных и чувствительных методов выявления грибов рода Candida в образцах тканей и кале. В общем анализе крови при тяжелых формах заболевания определяется уменьшение количества лейкоцитов, лимфоцитов, эритроцитов. Обязательна консультация врача-эндоскописта для выбора оптимального метода исследования кишечника. Во время эндоскопии обычно обнаруживают неспецифические признаки поражения слизистой, поэтому решающее значение в постановке диагноза имеет эндоскопическая биопсия и морфологическое исследование биоптатов.
Трудности диагностики заключаются в том, что псевдомицелий грибов можно выявить не во всех пробах материала, поэтому достаточно часто встречаются ложноотрицательные результаты. Визуально при диффузном инвазивном кандидозе кишечника определяются признаки язвенно-некротического поражения слизистой, а при неинвазивном - катаральное воспаление. Диагностическим критерием инвазивного кандидоза кишечника служит наличие кандидозного псевдомицелия в биоптатах и отпечатках слизистой оболочки кишки.
Всем пациентам с грибковым поражением кишечника обязательно проводится анализ кала на дисбактериоз, бактериологическое исследование кала. Чаще всего эти анализы выявляют смешанную флору: не только грибы рода Candida, но и кишечную палочку, клебсиеллы, стафилококки и др. Выявление более 1000 колониеобразующих единиц на грамм патологического материала свидетельствует в пользу кандидоза кишечника и исключает носительство грибковой флоры. Основной задачей культурального исследования является установление вида возбудителя, определение чувствительности выделенной микрофлоры к антимикотикам.
Лечение кандидоза кишечника
Консультация гастроэнтеролога при кандидозе кишечника позволяет выявить факторы риска данного заболевания, определить объем необходимых исследований. Так как кандидоз кишечника не имеет специфических клинических признаков, заподозрить эту патологию бывает достаточно сложно. При наличии лабораторных свидетельств кандидоза кишечника выбор тактики лечения зависит от клинического варианта, наличия сопутствующей патологии, переносимости антимикотических препаратов. Обязательными звеньями лечебного процесса при кандидозе кишечника являются: коррекция фонового заболевания, приведшего к снижению иммунитета и активации грибковой флоры; назначение целевого противогрибкового средства; модуляция иммунитета.
Пациенты с диффузной инвазивной формой кандидоза кишечника госпитализируются в стационар. Препаратами выбора для инвазивных микозов являются азольные антимикотики (кетоконазол, флуконазол, итраконазол и пр.), которые активно всасываются из кишечника и оказывают системное действие. Начинают лечение обычно с введения амфотерицина В, затем переходят на терапию флуконазолом.
Для эрадикации грибковой флоры при неинвазивных формах кандидоза кишечника используют противогрибковые препараты нерезорбтивного действия - они плохо всасываются слизистой оболочкой кишки и оказывают сильное местное действие. Нерезорбтивные полиеновые антимикотики имеют ряд преимуществ - у них практически нет побочных действий, они не угнетают нормальную микрофлору кишечника, не вызывают привыкания. К полиеновым препаратам относят натамицин, нистатин. Так как в патогенезе неинвазивного кандидоза имеют значение состояние дисбиоза и смешанная флора, обязательно назначают противомикробные препараты, эубиотики. В качестве симптоматического лечения применяют пищеварительные ферменты, сорбенты, спазмолитики и анальгетики.
Прогноз и профилактика
При диффузной инвазивной форме кандидоза кишечника прогноз серьезный, так как она может приводить к генерализации процесса. Прогноз при инвазивном кандидозе кишечника значительно отягощается наличием тяжелых фоновых заболеваний. При остальных вариантах заболевания прогноз благоприятный при своевременном начале лечения.
Профилактика кандидоза кишечника заключается в устранении предрасполагающих к этой патологии факторов; лечении заболеваний пищеварительного тракта, приводящих к дисбиозу. Для поддержания нормальной микрофлоры кишечника следует разнообразно питаться, ограничивая содержание простых углеводов, употреблять достаточное количество клетчатки. Пациенты, входящие в группу риска по развитию кандидоза органов ЖКТ (ВИЧ, тяжелая эндокринная патология, полихимиотерапия, лечение кортикостероидными гормонами и пр.), требуют пристального внимания и регулярного обследования.
Кандидоз
Информацию из данного раздела нельзя использовать для самодиагностики и самолечения. В случае боли или иного обострения заболевания диагностические исследования должен назначать только лечащий врач. Для постановки диагноза и правильного назначения лечения следует обращаться к Вашему лечащему врачу.
Для корректной оценки результатов ваших анализов в динамике предпочтительно делать исследования в одной и той же лаборатории, так как в разных лабораториях для выполнения одноименных анализов могут применяться разные методы исследования и единицы измерения.
Кандидоз: причины появления, симптомы, диагностика и способы лечения.
Кандидоз - инфекционное заболевание, вызываемое дрожжеподобными грибками рода Candida. Оно обусловлено активным размножением грибка на слизистых оболочках полости рта, половых и внутренних органов и на коже.
Все представители рода Candida относятся к условно-патогенным микроорганизмам, то есть они постоянно присутствуют в составе нормальной микрофлоры. Но при снижении иммунитета, изменении гормонального фона и по ряду других причин эти грибки могут начать активно колонизировать слизистые оболочки и кожу.
Наиболее распространенные представители рода - Candida albicans и C. tropicalis. В 90-95% случаев урогенитального кандидоза именно C. albicans является доминирующим возбудителем.
![shutterstock_714362212 [преобразованный].jpg](/pimg3/infektsii-drozhzhevix-gribov-D40CE07.jpg)
Первый контакт с грибками рода Candida происходит во время прохождения ребенка по родовым путям. Однако в медицинской литературе описаны случаи обнаружения этих микроорганизмов в околоплодных водах, что свидетельствует о возможности вертикального (трансплацентарного) пути передачи. Также встречается передача грибка рода Candida при грудном вскармливании, кожном контакте ребенка с матерью, бытовым и пищевым путями.
Эти микроорганизмы вырабатывают эндотоксины и ферменты, вызывающие гибель клеток и некроз тканей, что способствует усилению адгезивной (прикрепление к клеткам слизистых оболочек или кожи) способности грибка и обеспечивает проникновение в ткани.
Гиперпродукция этих и ряда других веществ обуславливает патогенность представителей семейства Candida.
Причины возникновения кандидоза
По локализации процесса выделяют:
Урогенитальный кандидоз (УГК) - широко распространенное заболевание: по данным медицинской статистики, около 75% женщин репродуктивного возраста хотя бы единожды регистрировали у себя симптомы УГК.
Выделяют острую и хроническую форму урогенитального кандидоза, кандидоз вульвы, вагины и других урогенитальных локализаций. В ряде случаев при диагностике используют уточнение: осложненный или неосложненный УГК, что отражает количество обострений в год и степень выраженности заболевания.
Симптомы женского урогенитального кандидоза
Межпальцевый кандидоз локализуется в пространстве между пальцами. При этом отмечается покраснение участков кожи с последующим появлением пузырьков в прозрачным содержимым. Заболевание быстро распространяется в тесных коллективах (в детских садах, школах и т. д.).
Кандидоз слизистой оболочки полости рта (КСОПР)
Кандидоз полости рта вызывает неприятные ощущения, особенно при приеме пищи - жжение, боль, сухость. В зависимости от локализации процесса выделяют несколько форм кандидоза полости рта.
Часто КСОПР и желудочно-кишечного тракта сопровождает иммунодефицитные состояния: ВИЧ-инфекцию, синдром приобретенного иммунодефицита человека (СПИД) или врожденный иммунодефицит (например, при патологии Т-лимфоцитов). При наличии этих заболеваний кандидоз протекает с максимально выраженными симптомами, с трудом поддается лечению, носит агрессивный характер.
Самое частое проявление КСОПР - кандидозный стоматит, поражающий в основном грудных детей и взрослых с ослабленным иммунитетом.
При этой патологии слизистая оболочка полости рта краснеет, отекает, на ней появляются белесоватые пленки, имеющие творожистую консистенцию. На начальных стадиях болезни налет легко снимается. С течением заболевания пленки становятся плотнее, отделяются с трудом, при снятии обнажается кровоточащая слизистая оболочка.
При кандидозном стоматите возможно поражение языка, что проявляется покраснением спинки языка, появлением налета и слущиванием эпителия. Эти симптомы сопровождаются сильными болевыми ощущениями пораженной области при разговоре, приеме пищи и при пальпации (прощупывании) языка.
У курильщиков чаще других видов КСОПР развивается хронический гиперпластический кандидоз, сопровождаемый образованием белых, сливающихся между собой бляшек, которые возвышаются над поверхностью гиперемированной слизистой.
При этой патологии изменяется консистенция слюны: она становится вязкой и пенящейся; появляются неприятный запах изо рта, налет на слизистой серого или белого цвета. В 10-40% случаев эта клиническая форма кандидоза малигнизируется (т. е. приобретает злокачественный характер).
У пожилых людей чаще всего развивается хроническая атрофическая форма кандидоза полости рта. Слизистая оболочка при этом краснеет и отекает. Поражение часто локализуется под зубными протезами, что вызывает болевые ощущения.
Кандидозный хейлит и кандидоз углов рта в основном встречаются у детей и пожилых. Поражение обычно двустороннее, при этом образуются красные болезненные трещины в углах рта, покрытые легко снимающимся белым налетом или чешуйками. При длительном течении заболевания возможно присоединение бактериальной инфекции.
Диагностика кандидоза
Алгоритм диагностического поиска при кандидозе любой локализации включает в себя взятие материала с пораженной области с последующей его микроскопией, посевом для определения вида грибка и его чувствительности к антимикотическим (противогрибковым) препаратам.
В целях диагностики состояний, приведших к снижению иммунитета, используется общий анализ крови;
Синонимы: Общий анализ крови, ОАК. Full blood count, FBC, Complete blood count (CBC) with differential white blood cell count (CBC with diff), Hemogram. Краткое описание исследования Клинический анализ крови: общий.

В норме грибы рода Candida присутствуют на коже и слизистых оболочках здоровых людей, не причиняя беспокойства. Если по какой-то причине иммунитет ослабевает, грибы могут начать активный рост — это провоцирует воспаление, которое нужно лечить.
Что такое кандидоз кишечника
Кандидоз кишечника — это воспаление слизистой оболочки кишечника, вызванное грибковой инфекцией.
Грибы рода Candida относятся к условно-патогенным организмам. Это значит, что в небольших количествах они присутствуют в организме здорового человека, не вызывая неприятных симптомов. Но если иммунитет снижается, они начинают активно размножаться, провоцируя воспаление. В этом случае говорят о кандидозе.
При снижении общего иммунитета кандидоз не только развивается в кишечнике, но и поражает другие органы, например гениталии, бронхи, носоглотку.
Когда грибы активно размножаются, воспаление сопровождается образованием на слизистых оболочках белого налёта или появлением белых творожистых выделений. Поэтому заболевание получило название «молочница».
В норме грибы рода Candida находятся в кишечнике в небольшом количестве. Если же они активируются и начинают размножаться, развивается кандидоз.
Воспаление, которое возникает при реактивации собственных условно-патогенных организмов, называется аутоинфекция.
Кишечный кандидоз развивается на фоне снижения иммунитета. Этому может способствовать множество факторов.
Факторы, влияющие на развитие кандидоза кишечника:
Течение кандидоза кишечника
В норме микроскопические грибы рода Candida в небольшом количестве могут присутствовать на слизистых оболочках желудочно-кишечного тракта. От активного роста их сдерживает полезная флора, населяющая кишечник.
При снижении местного или общего иммунитета сдерживающая функция флоры ослабевает и грибы переходят к активному росту.
В большинстве случаев грибковая инфекция протекает неинвазивно, то есть развивается в просвете кишечника, не проникая в ткани. В процессе жизнедеятельности грибы выделяют токсины, которые раздражают слизистую оболочку и вызывают ухудшение самочувствия с признаками расстройства кишечника.
Если целостность слизистой оболочки нарушена (например, при язвенной болезни), возможно локальное проникновение инфекции в ткани кишечника.
При значительном снижении иммунитета (например, при заражении вирусом иммунодефицита человека) грибы проникают в ткани кишечника, а затем в кровоток. По мере распространения инфекции воспаление переходит в опасную для жизни генерализованную форму с поражением печени, головного мозга, сердца и других внутренних органов (грибковый сепсис).
Название «молочница» заболевание получило из-за строения грибов: размножаясь, они образуют белый налёт на слизистых оболочках и вызывают творожистые выделения.
Виды кандидоза кишечника
Кандидоз кишечника классифицируют по распространённости и характеру поражения тканей:
Кандидоз кишечника может распространяться на другие органы желудочно-кишечного тракта, вызывая кандидоз желудка и пищевода.
Симптомы зависят от формы течения заболевания и степени поражения тканей и органов. Специфических признаков, однозначно указывающих на то, что кандида вызвала воспаление в кишечнике, не существует.
В большинстве случаев инфекция протекает в неинвазивной форме и сопровождается неприятными ощущениями в животе, метеоризмом и нарушениямиями стула. Возможно незначительное ухудшение общего самочувствия из-за интоксикации: тошнота, головная боль.
При инвазивных формах кандидоз сопровождается резким ухудшением самочувствия с повышением температуры, сильной болью в животе и расстройством стула. Возможны примеси крови в кале и признаки поражения других органов пищеварительной системы — печени, жёлчного пузыря, поджелудочной.
Возможные симптомы при кандидозе кишечника:
У женщин кандидозу кишечника часто сопутствует вагинальный кандидоз: он сопровождается жжением, зудом и творожистыми выделениями из влагалища.
Осложнения кандидоза кишечника
При своевременной диагностике и соблюдении назначений врача кандидоз кишечника редко вызывает осложнения.
Но при отсутствии лечения (или при попытке лечить воспаление самостоятельно) инфекция может распространяться на органы других систем — мочевыделительной, репродуктивной. В результате могут пострадать уретра, мочевой пузырь, почки, у женщин — влагалище, шейка матки, маточные трубы и яичники. Без лечения эти патологии могут привести к бесплодию.
У людей со сниженным иммунитетом инфекция при кандидозе кишечника может переходить в генерализованную форму, вызывая заражение крови и поражая мозг, сердце и другие органы.
У беременных кандидоз может приводить к преждевременным родам или внутриутробному заражению плода. Такое состояние опасно для жизни ребёнка.
Диагностика кандидоза кишечника
Так как грибы рода Candida относятся к условно-патогенным микроорганизмам и в норме присутствуют на коже и слизистых оболочках организма, лечить их нужно только при наличии признаков воспаления. Это значит, что сдавать анализы на кандидоз в профилактических целях не имеет смысла.
При подозрении на кандидоз кишечника врач назначает исследования, чтобы определить, вызвано ли воспаление грибковой инфекцией, и узнать, какая разновидность грибов его спровоцировала (наиболее частые возбудители — это Candida tropicalis и Candida albicans). Также анализ определяет чувствительность возбудителя к лекарственным препаратам — от этого показателя зависит выбор лекарства.
Поскольку кандидоз кишечника нередко сопровождается бактериальным воспалением — ростом стафилококков, кишечной палочки и других микроорганизмов, — вместе с посевом назначают анализ кала на дисбактериоз и бактериологическое исследование кала.
Читайте также:
